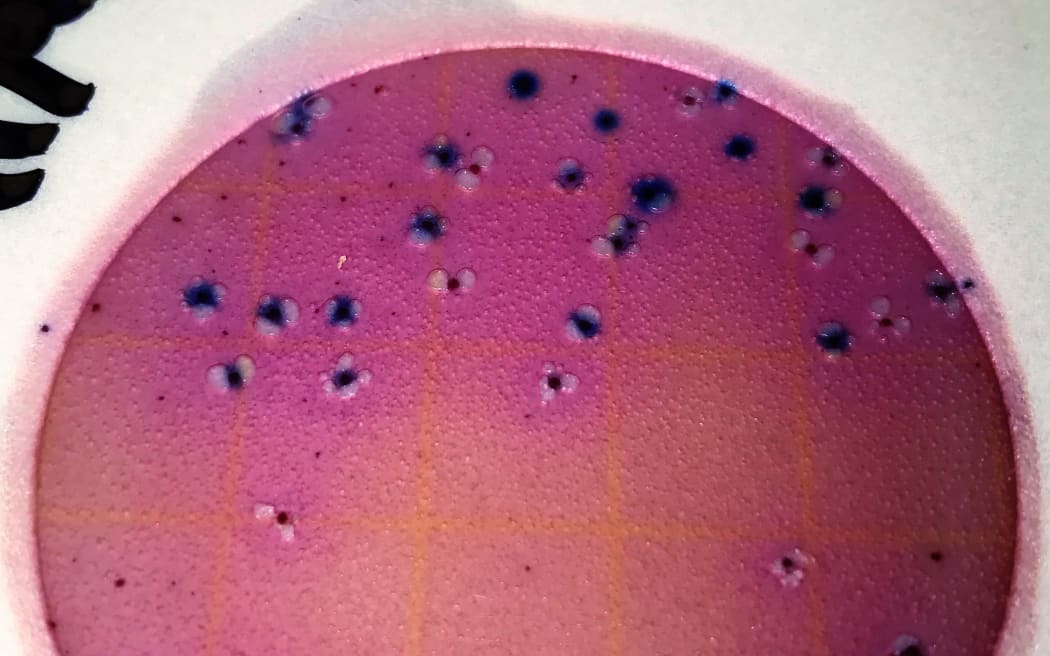
No caption

Afternoons for Friday 7 October 2022

COTW t-shirt 2022 Photo: supplied
Hey COTW fans - critter t-shirts are back with a new design and a tote bag.
The money raised from the sale of the products goes directly to community environmental groups.
You can pre-order your t-shirts, tote bags and tea towels via the link below. You have two weeks to place your orders so they arrive in time for Christmas.
https://joyya.nz/critter-of-the-week/
1:10 First song: From rugby playing to guitar playing
Ōtautahi's Sam Heselwood has released his first EP today.
He turned to music after an injury put and end to his burgeoning professional rugby career.
Sam talks to Jesse about the change from playing on the field to playing for audiences on stage. We also hear one of his tracks, 'Four'.

Photo: SOLE Music Academy
1:15 New app to help early diagnosis of Parkinson's disease
A new app records your voice, and takes 10 seconds to reveal whether you might have Parkinson's disease.
It's currently diagnosed by a 90 minute evaluation with a neurologist.
Professor Dinesh Kumar from Royal Melbourne Institute of Technology started the study 7 years ago. He talks to Jesse about the app and how it can help with Parkinson's diagnoses.

Photo: 123RF
1:25 Whanganui River Boat Festival
A big weekend ahead for boat enthusiasts and history buffs.
Whanganui is kicking off its Heritage Month with a river boat festival tomorrow.
It is likely to be the biggest river boat festival ever held on the Whanganui River.
Event founder Helen Craig talks to Jesse.

Whanganui River steam boat Photo: supplied
1:35 New Zealand invention revolutionalising E.coli testing
Testing for E. coli in drinking water can take days, and costs a lot of money.
This leads to frequent illnesses and enormous economic losses according to Dr Alex Risos of the University of Auckland.
He's a finalist in the KiwiNet Research Commercialisation Awards 2022, with his new technology to revolutionise water safety.
Dr Risos talks to Jesse about how his technology works.
Photo: Supplied
1:45 Hawkes Bay school children collect nearly 3 tonnes of lids and caps
In just 10 weeks Hawkes Bay school children have managed to collect 2.8 tonnes of lids and caps in a pilot recycling initiative.
Good Caps is an initiative led by Plastics NZ and a dozen schools participated with the aim to stop these valuable materials going to landfill.
One of those students who took part is eight year old Jasper from Havelock North Primary. He talks to Jesse about being part of the project.

Bags of caps and lids Hawkes Bay children diverted from the landfill Photo: supplied
2:10 Film Review with Dom Corry
Today Dom talks to Jesse about 'Amsterdam', a period caper film starring Christian Bale and Margot Robbie. It's out in cinemas today. He also gives his thoughts on Memory, a new Liam Neeson action thrilled available on Prime Video from today.
2:20 NZ Live: Ainslie Allen
Ainslie Allen became a household name in the 1990s when, aged 16, she was thrust into the spotlight on the McDonald's Young Entertainers television show.
Although many of her fans might know her for performing pop cover songs, Ainslie has long been a fan of alternative country music and last year released an album - Betty.
She's in to perform for NZ Live today.

Ainslee Allen and band Photo: RNZ
3:08 One Hour Spring Focaccia Bread
Today Jess Daniell of Jess's Underground Kitchen shares a recipe that straddles the funny season that is spring.
She's got an easy bread recipe that turns out perfect every time. You then add in seasonal vegetables to give it an extra twist.
You can find out how to make her One Hour Spring Focaccia Bread here.

One Hour Spring Focaccia Bread Photo: Jess Daniell
3:16 Music 101: Charlotte Ryan
Charlotte Ryan, host of Music 101 here on RNZ each Saturday afternoon from 1pm talks about what's happening on the music scene over the weekend, what's coming up on her show tomorrow and because Friday is new music day - she'll pick us a track to play.

Photo: RNZ / Claire-Eastham Farrelly
3:25 DIY with builder Stan Scott
3:35 Critter of the Week: Marine caddisflies
Caddisflies are common to healthy streams and waterways but how not many people know that we also boast some of the only marine caddisflies in the world!

Marine caddisflies Photo: supplied
3:45 The Panel with Alexia Russell and Ed Amon






